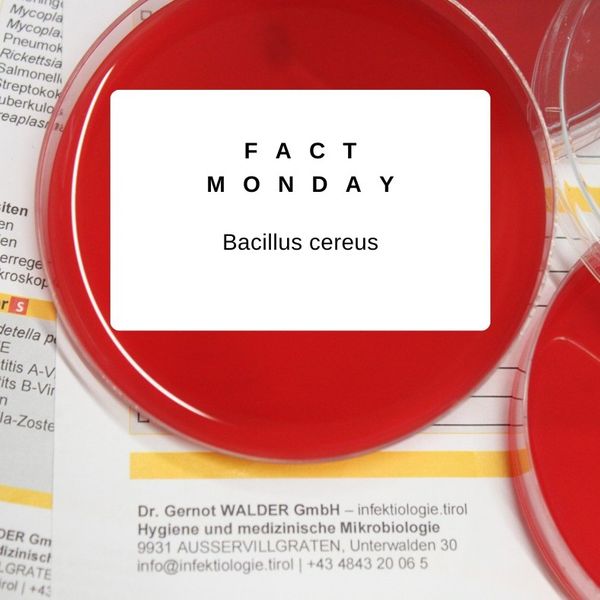

Dengue-Virus
#factmonday – Dengue-Virus

#factmonday – Dengue-Virus

die 3 Grundformen

#factmonday – Shigellen

Aufbau & Funktion

das Trinkwasser testen zu lassen

ein Leben für Mikroben
#factmonday – Bacillus cereus

5. Mai

Staphylococcus aureus

der Hände 🤲